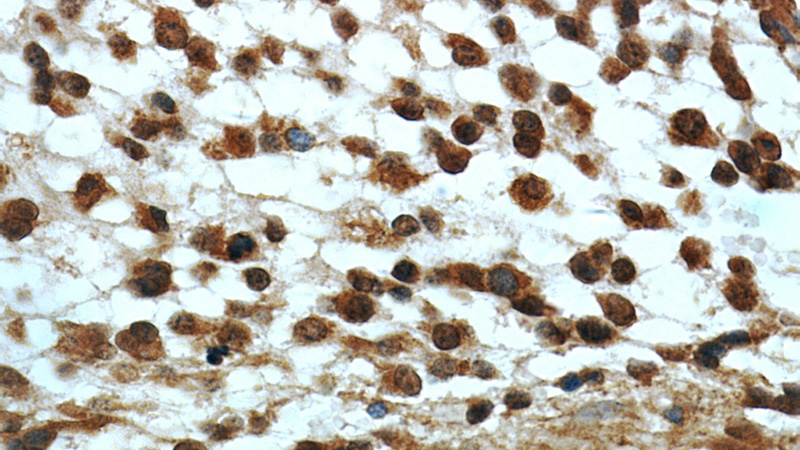
Immunohistochemical of paraffin-embedded human gliomas using Catalog No:107424(MGEA5 antibody) at dilution of 1:50 (under 40x lens)

-
Product Name
MGEA5 antibody
- Documents
-
Description
MGEA5 Mouse Monoclonal antibody. Positive IHC detected in human meningioma tissue, human brain tissue, human gliomas tissue. Positive IF detected in HepG2 cells, Hela cells. Positive WB detected in Human brain tissue, human liver tissue. Observed molecular weight by Western-blot: 75kD,130kD
-
Tested applications
ELISA, WB, IF, IHC
-
Species reactivity
Human; other species not tested.
-
Alternative names
Beta N acetylhexosaminidase antibody; Bifunctional protein NCOAT antibody; FLJ11229 antibody; FLJ23355 antibody; HAT antibody; HEXC antibody; Hexosaminidase C antibody; KIAA0679 antibody; MEA5 antibody; Meningioma expressed antigen 5 antibody; MGEA5 antibody; N acetyl beta glucosaminidase antibody; NCOAT antibody; O GlcNAcase antibody; OGA antibody
- Immunogen
-
Isotype
Mouse IgG1
-
Preparation
This antibody was obtained by immunization of MGEA5 recombinant protein (Accession Number: BC039583). Purification method: Protein G purified.
-
Clonality
Monoclonal
-
Formulation
PBS with 0.02% sodium azide and 50% glycerol pH 7.3.
-
Storage instructions
Store at -20℃. DO NOT ALIQUOT
-
Applications
Recommended Dilution:
WB: 1:200-1:2000
IHC: 1:20-1:200
IF: 1:20-1:200
-
Validations

Human brain lysate were subjected to SDS PAGE followed by western blot with Catalog No:107424(MGEA5 antibody) at dilution of 1:600
Immunohistochemical of paraffin-embedded human gliomas using Catalog No:107424(MGEA5 antibody) at dilution of 1:50 (under 40x lens)

Immunohistochemistry of paraffin-embedded human meningioma tissue slide using Catalog No:107424(MGEA5 Antibody) at dilution of 1:200 (under 10x lens). Heat mediated antigen retrieved with Citric acid buffer, pH6.0.

Immunohistochemistry of paraffin-embedded human meningioma tissue slide using Catalog No:107424(MGEA5 Antibody) at dilution of 1:200 (under 40x lens). Heat mediated antigen retrieved with Citric acid buffer, pH6.0.

Immunofluorescent analysis of HepG2 cells using Catalog No:107424(MGEA5 Antibody) at dilution of 1:50 and Rhodamine-Goat anti-Mouse IgG
-
Background
Human meningioma-expressed antigen 5 (MGEA5) has two putative domains including protein O-GlcNAcase domain and histone acetyltransferase domain, therefore it is often called bifunctional protein NCOAT. Three isoforms of MEGE5 are produced by alternative splicing. MGEA5 was found to be regulated to reduce the state of glycosylation of transcitpional activators while increasing the acetylation of histones to allow for the concerted activation of eukaryotic gene transcription, for instance, acetylation of Lys8 of histone H4 and Lys 14 of histone H3 are resulted from acetyltransferase activity. In addition, single nucleotide polymorphism in MGE5A is associated with type 2 diabetes in Mexican Americans. Two bands at 130kDa and 75 kDa could be detected using the present mouse monopolyclonal antibody 66033-1-Ig, which is consistent with results in a related reference (PubMed:11341771).
Related Products / Services
Please note: All products are "FOR RESEARCH USE ONLY AND ARE NOT INTENDED FOR DIAGNOSTIC OR THERAPEUTIC USE"
